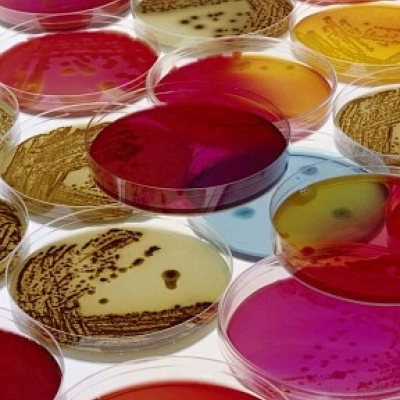

|
||||||||
|
|
||||||||
|
Your time 00:00
|
||||||||
|
Average time
00:54
|
||||||||
|
Best time
01:46
|
||||||||
 |
||||||||
|
|
||||||||
|
||||||||||||||||||||||||||||
BIOTECNOLOGIAThis puzzle belongs to user album My Album Album's Owner: Stephania38
Image credit and copyright: QUIMICA |
||||||
| BIOTECNOLOGIA - 25 Pieces | |||||
| Your time: |
|
||||
| Show larger puzzle pieces behind smaller pieces? Yes No | |
| Share this puzzle |
|
| |